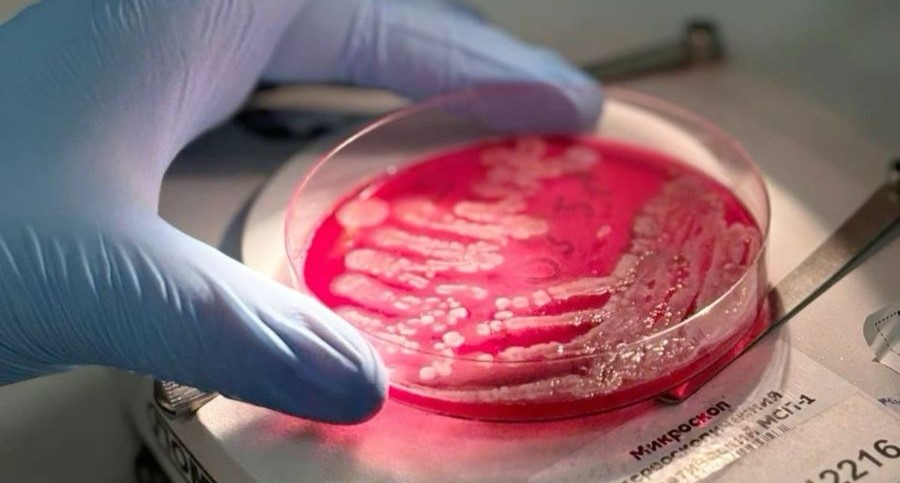

La conservation des produits cosmétiques : maîtrise microbiologique et exigences réglementaires
Introduction
La conservation des produits cosmétiques constitue un enjeu majeur pour garantir leur sécurité tout au long de leur utilisation. Un produit stable sur le plan physico-chimique peut néanmoins devenir impropre à l’usage en cas de contamination microbienne.
La maîtrise de la conservation est donc indissociable de la stabilité et fait partie intégrante du développement et de la mise sur le marché d’un produit cosmétique.
La stabilité des produits cosmétiques : enjeux scientifiques et exigences réglementaires
Introduction
La stabilité d’un produit cosmétique constitue un critère fondamental : de sa qualité, sa sécurité et de sa conformité réglementaire. Un produit instable peut voir ses propriétés physico-chimiques évoluer au cours du temps, entraînant une perte d’efficacité, une modification sensorielle ou un risque pour le consommateur.
La maîtrise de la stabilité fait ainsi partie intégrante du rôle d’un laboratoire cosmétique, depuis la phase de développement jusqu’à la mise sur le marché.